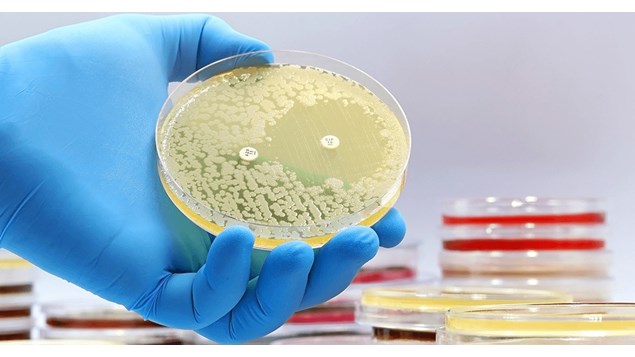

Så er der nyt fra Vejlby Apotek
Skal vi frygte antibiotikaresistens?
Siden midten af 1940-erne har antibiotika revolutioneret verden. Før antibiotika døde masser af mennesker på grund af lungebetændelse og andre almindelige infektioner. Men medaljen har en bagside. Antibiotika er blevet brugt ret ukritisk, og det har skabt et nyt problem: Antibiotikaresistens – dvs. at bakterier er modstandsdygtige over for antibiotika...
Læs mere i interviewet herunder, hvor fagchef for antibiotikaresistens på Statens Seruminstitut, Ute Wolff Sönksen, fortæller om hvad bakterier og antibiotika er, og hvordan deres samspil fungerer ↓
Siden midten af 1940-erne har antibiotika revolutioneret verden. Før antibiotika døde masser af mennesker på grund af lungebetændelse og andre almindelige infektioner. Men medaljen har en bagside. Antibiotika er blevet brugt ret ukritisk, og det har skabt et nyt problem: Antibiotikaresistens – dvs. at bakterier er modstandsdygtige over for antibiotika...
Læs mere i interviewet herunder, hvor fagchef for antibiotikaresistens på Statens Seruminstitut, Ute Wolff Sönksen, fortæller om hvad bakterier og antibiotika er, og hvordan deres samspil fungerer ↓
Vejlby Apotek er kommerciel partner med VORES Lystrup og oplysningerne er hentet fra deres Facebookside. Støt lokalt og giv en tommel op på deres side.
Se mere om Vejlby Apoteks på deres hjemmeside.
åbningstider
Mandag: 08:30 - 17:30
Tirsdag - Fredag: 09:00 - 17:30
Lørdag: 09:00 - 13:00
Søndag/Helligdage: Lukket






